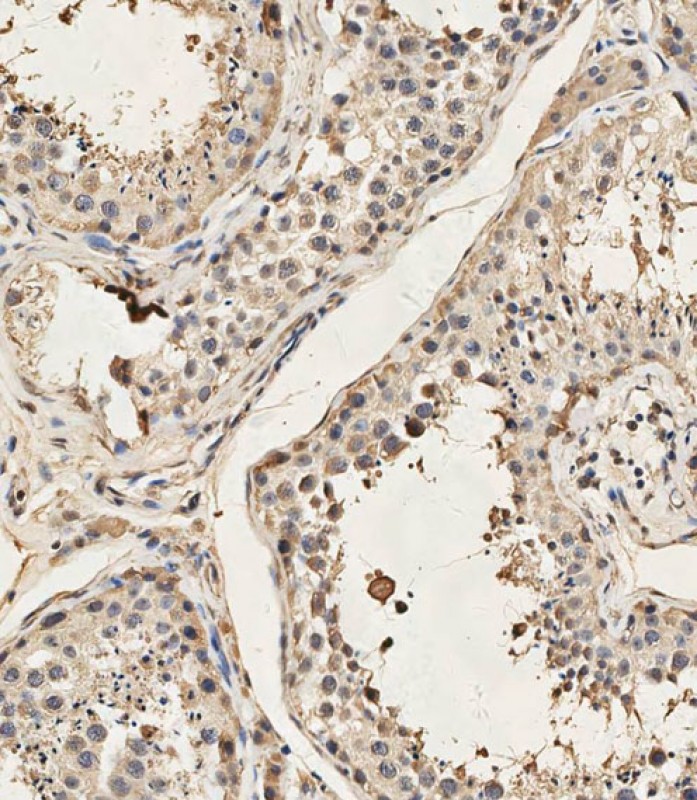

Mouse Dyrk2 Antibody (C-term)
Affinity Purified Rabbit Polyclonal Antibody (Pab)
- SPECIFICATION
- CITATIONS
- PROTOCOLS
- BACKGROUND

Application
| WB, IHC-P, E |
|---|---|
| Primary Accession | Q5U4C9 |
| Other Accession | NP_001014412.1 |
| Reactivity | Human, Mouse |
| Host | Rabbit |
| Clonality | Polyclonal |
| Isotype | Rabbit IgG |
| Calculated MW | 66556 Da |
| Antigen Region | 521-549 aa |
| Gene ID | 69181 |
|---|---|
| Other Names | Dual specificity tyrosine-phosphorylation-regulated kinase 2, Dyrk2 {ECO:0000312|MGI:MGI:1330301} |
| Target/Specificity | This Mouse Dyrk2 antibody is generated from rabbits immunized with a KLH conjugated synthetic peptide between 521-549 amino acids from the C-terminal region of mouse Dyrk2. |
| Dilution | WB~~1:2000 IHC-P~~1:100 E~~Use at an assay dependent concentration. |
| Format | Purified polyclonal antibody supplied in PBS with 0.09% (W/V) sodium azide. This antibody is purified through a protein A column, followed by peptide affinity purification. |
| Storage | Maintain refrigerated at 2-8°C for up to 2 weeks. For long term storage store at -20°C in small aliquots to prevent freeze-thaw cycles. |
| Precautions | Mouse Dyrk2 Antibody (C-term) is for research use only and not for use in diagnostic or therapeutic procedures. |
| Name | Dyrk2 {ECO:0000312|MGI:MGI:1330301} |
|---|---|
| Function | Serine/threonine-protein kinase involved in the regulation of the mitotic cell cycle, cell proliferation, apoptosis, organization of the cytoskeleton and neurite outgrowth. Functions in part via its role in ubiquitin-dependent proteasomal protein degradation. Functions downstream of ATM and phosphorylates p53/TP53 at 'Ser-46', and thereby contributes to the induction of apoptosis in response to DNA damage. Phosphorylates NFATC1, and thereby inhibits its accumulation in the nucleus and its transcription factor activity. Phosphorylates EIF2B5 at 'Ser-544', enabling its subsequent phosphorylation and inhibition by GSK3B. Likewise, phosphorylation of NFATC1, CRMP2/DPYSL2 and CRMP4/DPYSL3 promotes their subsequent phosphorylation by GSK3B. May play a general role in the priming of GSK3 substrates. Inactivates GYS1 by phosphorylation at 'Ser-641', and potentially also a second phosphorylation site, thus regulating glycogen synthesis. Mediates EDVP E3 ligase complex formation and is required for the phosphorylation and subsequent degradation of KATNA1. Phosphorylates TERT at 'Ser-457', promoting TERT ubiquitination by the EDVP complex. Phosphorylates SIAH2, and thereby increases its ubiquitin ligase activity. Promotes the proteasomal degradation of MYC and JUN, and thereby regulates progress through the mitotic cell cycle and cell proliferation. Promotes proteasomal degradation of GLI2 and GLI3, and thereby plays a role in smoothened and sonic hedgehog signaling. Phosphorylates CRMP2/DPYSL2, CRMP4/DPYSL3, DCX, EIF2B5, EIF4EBP1, GLI2, GLI3, GYS1, JUN, MDM2, MYC, NFATC1, p53/TP53, TAU/MAPT and KATNA1. Can phosphorylate histone H1, histone H3 and histone H2B (in vitro). Can phosphorylate CARHSP1 (in vitro) (By similarity). Plays a role in cytoskeleton organization and neurite outgrowth via its phosphorylation of DCX. |
| Cellular Location | Cytoplasm. Nucleus {ECO:0000250|UniProtKB:Q92630}. Note=Translocates into the nucleus following DNA damage. {ECO:0000250|UniProtKB:Q92630} |

Thousands of laboratories across the world have published research that depended on the performance of antibodies from Abcepta to advance their research. Check out links to articles that cite our products in major peer-reviewed journals, organized by research category.
info@abcepta.com, and receive a free "I Love Antibodies" mug.
Provided below are standard protocols that you may find useful for product applications.
Background
Role in the regulation of cellular growth and/or development. Regulates TP53 by phosphorylation on Ser-46 to induce apoptosis in response to DNA damage, functioning downstream of ATM. Inactivates GYS1 by phosphorylation at Ser-641, and potentially also a second phosphorylation site, thus regulating glycogen synthesis. Phosphorylates EIF2B5 at Ser-544, enabling its subsequent phosphorylation and inhibition by GSK3, and may play a more general role in the priming of GSK3 substrates (By similarity).
References
Guo, X., et al. J. Biol. Chem. 285(17):13223-13232(2010)
Kudo, L.C., et al. Cereb. Cortex 17(9):2108-2122(2007)
Blackshaw, S., et al. PLoS Biol. 2 (9), E247 (2004) :
Clark, A.G., et al. Science 302(5652):1960-1963(2003)
Geiger, J.N., et al. Blood 97(4):901-910(2001)
If you have used an Abcepta product and would like to share how it has performed, please click on the "Submit Review" button and provide the requested information. Our staff will examine and post your review and contact you if needed.
If you have any additional inquiries please email technical services at tech@abcepta.com.





Foundational characteristics of cancer include proliferation, angiogenesis, migration, evasion of apoptosis, and cellular immortality. Find key markers for these cellular processes and antibodies to detect them.
The SUMOplot™ Analysis Program predicts and scores sumoylation sites in your protein. SUMOylation is a post-translational modification involved in various cellular processes, such as nuclear-cytosolic transport, transcriptional regulation, apoptosis, protein stability, response to stress, and progression through the cell cycle.
The Autophagy Receptor Motif Plotter predicts and scores autophagy receptor binding sites in your protein. Identifying proteins connected to this pathway is critical to understanding the role of autophagy in physiological as well as pathological processes such as development, differentiation, neurodegenerative diseases, stress, infection, and cancer.